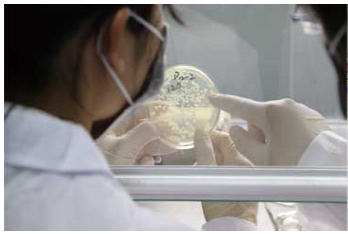
膜清洗劑生產廠家

碟管式反滲透工藝是基于碟管式反滲透膜的工藝運用,其核心技術在于碟管式反滲透膜對于系統而言是一個獨特的結構形式,能夠使反滲透膜直接對高濃度有機廢水進行處理,是一種相對而言穩定且可靠的處理技術,具備投資省、自控程度高以及穩定持續滿足排放要求的特點。
對于傳統的生化工藝而言DTRO系統有著占地面積小、運行靈活、建設周期短、對各污染物都具有較高的去除率、可移動性強等優勢,
DTRO系統的處理效果不依賴于滲瀝液的可生化性,故適用于不同時期的垃圾滲瀝液,且均具有系統運行穩定、處理效率高、出水水質良好等特點。DTRO系統占地面積小,安裝方便,可根據工程的實際情況,因地制宜,結合不同預處理及濃縮液處理方式。同時,基于DTRO工藝的滲瀝液處理集成系統也為擬封場填埋場的存量滲瀝液處理提供了有效的解決方案。
相關內容————微濾和超濾的概念
相關內容————微濾和超濾的概念
13602556382












